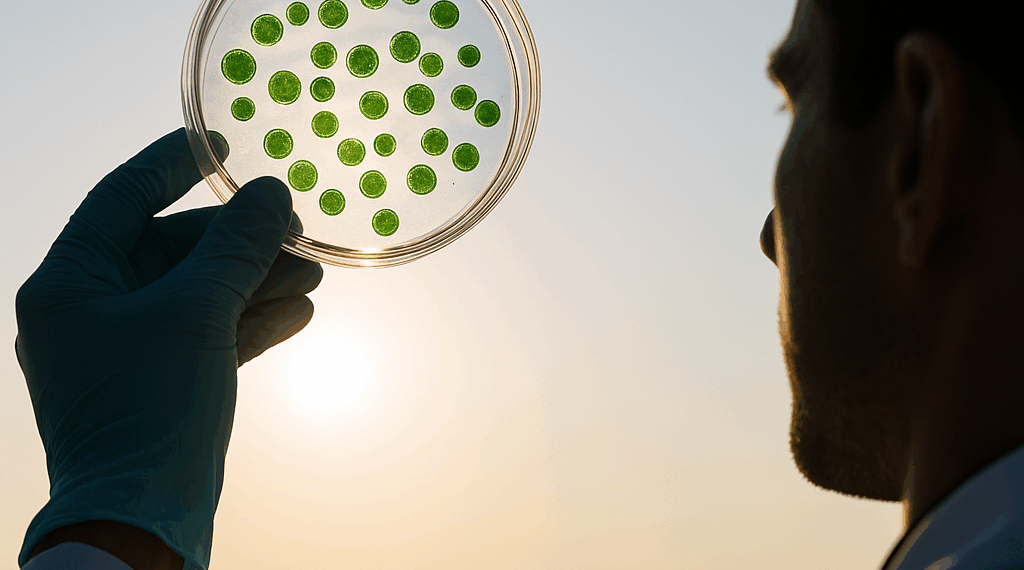
These Newly Discovered Cells Breathe in Two Ways

En un descubrimiento revolucionario en microbiología, un equipo de investigadores ha aislado una bacteria extraordinaria, conocida como RSW1, que posee la capacidad de respirar simultáneamente de dos maneras distintas. Este hallazgo se realizó en las aguas termales de Roadside West, en el Parque Nacional de Yellowstone, donde la vida microbiana es notablemente diversa y única.
El proceso de investigación comenzó cuando el equipo determinó las condiciones de crecimiento del RSW1. Se sabía que esta bacteria utilizaba oxígeno, por lo que se llevó a cabo una serie de experimentos en el laboratorio. Se constató que, en ausencia de oxígeno, el RSW1 podía utilizar hidrógeno gas y azufre elemental, generando sulfuro de hidrógeno como producto. Sin embargo, aunque la bacteria mantenía su vitalidad en estas condiciones, no se reproducía ni crecía eficazmente; simplemente lograba un nivel mínimo de energía suficiente para sobrevivir.
La sorpresa llegó cuando, al reintroducir el oxígeno en el entorno de cultivo, el RSW1 no solo aumentó su tasa de crecimiento, sino que también continuó produciendo sulfuro de hidrógeno, lo que indicaba que estaba llevando a cabo una respiración anaeróbica incluso en presencia de oxígeno. Este fenómeno de respiración dual, donde el microorganismo parece aprovechar simultáneamente los procesos aeróbicos y anaeróbicos, desafía las nociones convencionales sobre la biología de las bacterias.
Las implicaciones de este descubrimiento son significativas. Ranjani Murali, una microbióloga ambiental, subraya la rareza de un organismo capaz de manejar ambas formas metabólicas sin sufrir daño por compuestos reactivos de oxígeno, lo que añade un nuevo nivel de complejidad al entendimiento de cómo ciertos microorganismos se adaptan a entornos hostiles y fluctuantes. Este mecanismo podría ofrecer a RSW1 una ventaja competitiva en su hábitat, donde la disponibilidad de oxígeno es inconsistente.
Mientras que otras bacterias se han observado utilizando nitratos y oxígeno de manera simultánea, RSW1 distingue su metabolismo híbrido al integrar procesos que tradicionalmente se consideraban incompatibles. A diferencia de sus contrapartes, la respiración dual de RSW1 parece ser beneficiosa en lugar de perjudicial.
Los investigadores sugieren que la existencia de microorganismos con esta capacidad podría ser más común de lo que se pensaba, señalando entornos donde fluctúan los niveles de oxígeno, como ciertos sedimentos sumergidos. Algunos microbios, como las famosas “cable bacteria”, han desarrollado maneras de optimizar sus procesos metabólicos, pero RSW1 destaca por su habilidad para realizar ambas funciones a la vez en un entorno inestable y dinámico.
La naturaleza del metabolismo dual de RSW1 plantea preguntas intrigantes sobre la evolución microbiana, especialmente en el contexto del Gran Evento de Oxigenación, una época en la que la vida en la Tierra se vio forzada a adaptarse a la creciente presencia de oxígeno en la atmósfera. Para aquellos organismos que pudieron beneficiarse de esta nueva sustancia, el doble metabolismo podría haber sido una ventaja evolutiva considerable.
Este descubrimiento no solo ilumina aspectos fascinantes sobre la vida microbiana, sino que también abre la puerta a nuevas investigaciones sobre cómo se adaptan y sobreviven los organismos en condiciones extremas. A medida que se continúe explorando este dominio microbiano, es probable que surjan más sorpresas que desafíen nuestra comprensión de la viabilidad y la diversidad de la vida en nuestro planeta.
Gracias por leer Columna Digital, puedes seguirnos en Facebook, Twitter, Instagram o visitar nuestra página oficial. No olvides comentar sobre este articulo directamente en la parte inferior de esta página, tu comentario es muy importante para nuestra área de redacción y nuestros lectores.